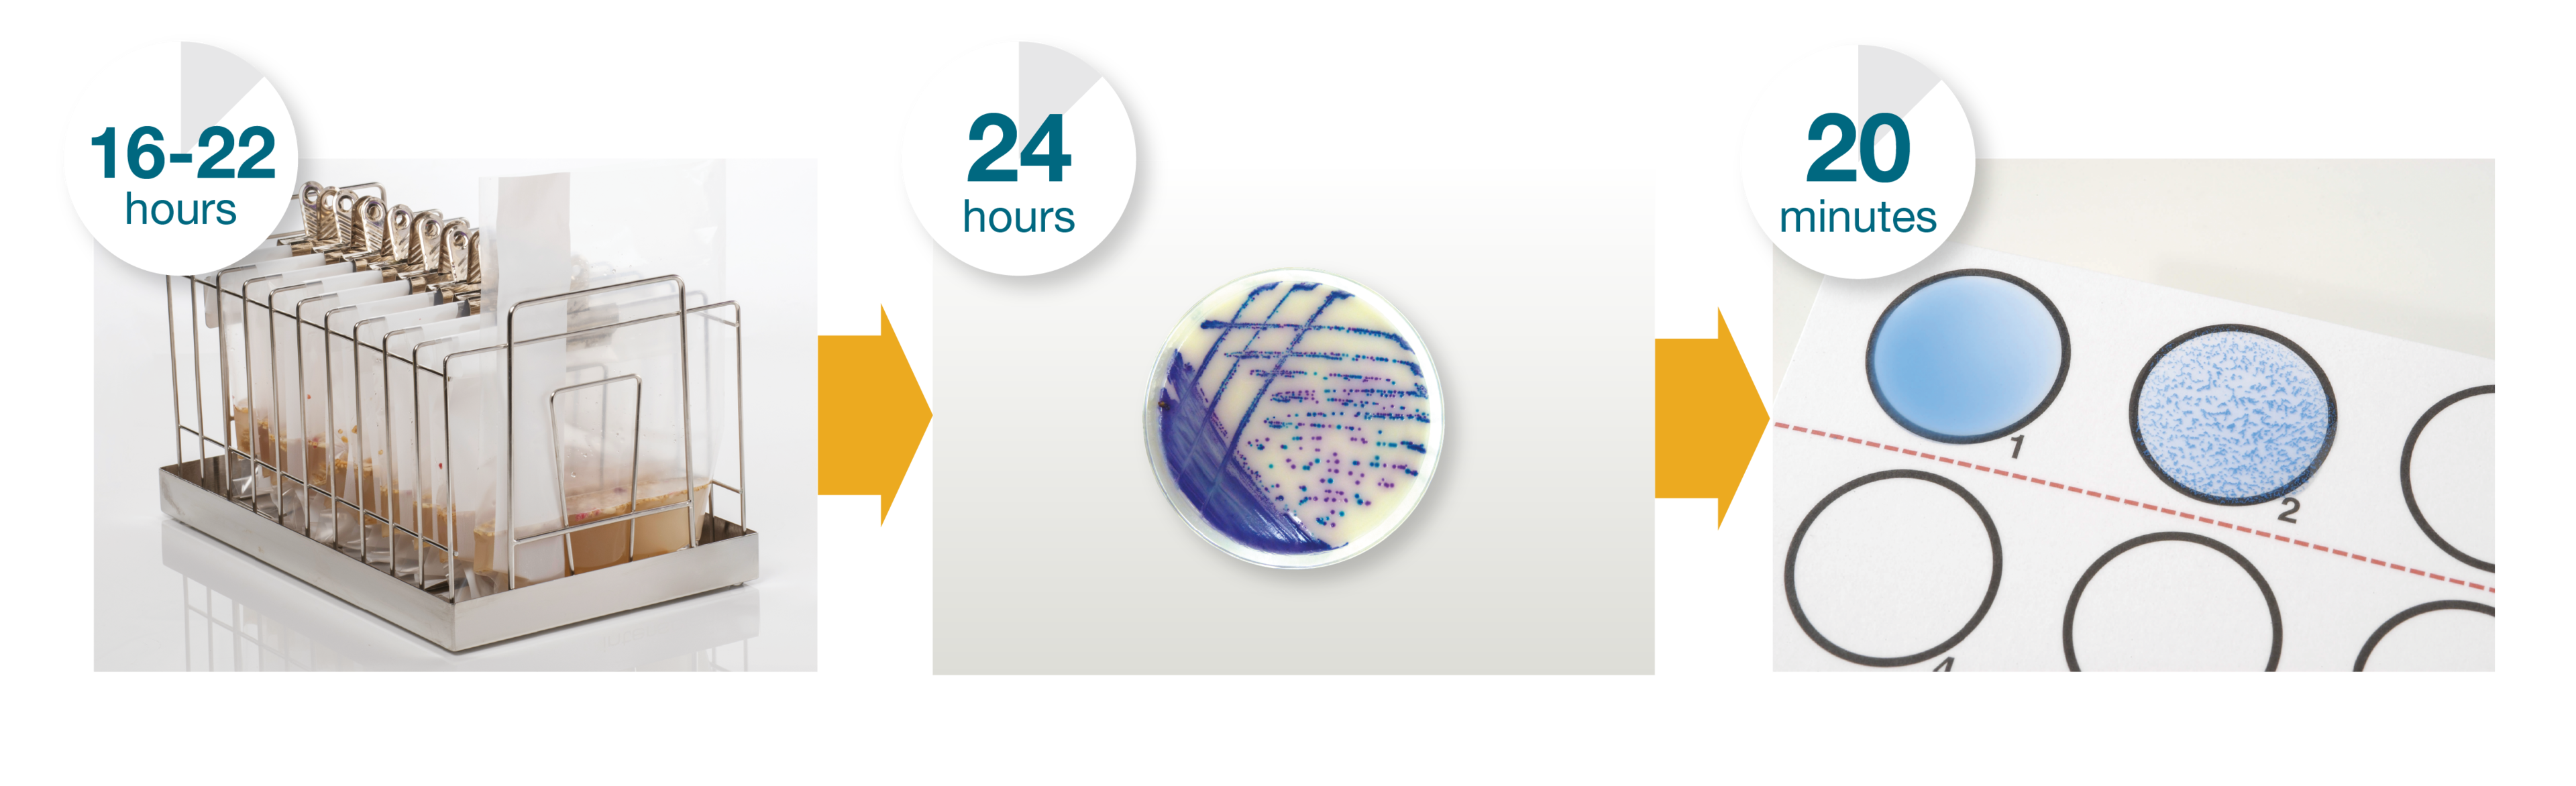
Thermo Scientific™ Salmonella Precis™ Method Thermo Scientific™ Salmonella Precis™ Method

Search
Search
沙门氏菌属属于肠杆菌科。沙门氏菌是革兰氏阴性杆菌,不会形成孢子。沙门氏菌具有 2,500 多个血清型,根据体细胞 (O) 和鞭毛 (H) 抗原进行鉴定。
沙门氏菌病是最常报道的食源性疾病的病因。据估计,美国每年发病病例数约 100 万例;其中约 35,000 例是向疾病控制和预防中心报告的实验室确诊病例。
摄入 1-10 个细胞即可达到人类感染剂量。低细胞数可能具有高度传染性,尤其是在高脂肪食物中,其中微生物可以逃避胃酸并通过胆汁介导的脂质分散释放到肠道中。
尽管普遍认为鸡肉和蛋制品是沙门氏菌感染的主要来源,但近年来的许多疫情均与番茄、花生酱和蔬菜芽苗有关。其他受影响的食物包括生肉、婴儿配方奶粉、牛奶和乳制品、鱼、虾、沙拉酱、蛋糕混合料和巧克力。
欧盟委员会法规 (EC) No 2073/2005 和其他国家法规和指南中引用的基于培养基的标准参考方法,用于检测一系列不同食品、动物饲料、环境样品和初级生产环境样品中的沙门氏菌属。
以下为 ISO6579 第 1 部分的摘要:在食品(包括牛奶和奶制品)、动物饲料、动物粪便和初级生产阶段的环境样品中检测沙门氏菌属。
第 0 天 |
|---|
25 g + 225 mL缓冲蛋白胨水 (BPW)
1 份拭子样品 + 10 mL BPW
1 份海绵涂抹样品 + 100 mL BPW
1 份擦拭样品 + 225 mL BPW
于 36±2°C 下培养 18±2 小时

第 1 天 |
|---|
向 10 mL Rappaport-Vassiliadis 蛋白胨大豆肉汤 (RVS) 或改良半固体 Rappaport Vassiliadis (MRSV) 琼脂中加入 100 μL 初级富集物。 于 41.5±1°C 下培养 24±3 小时
| 向 10 mL 添加了新生霉素和碘碘化物的 Muller-Kauffman 连四硫酸盐肉汤 (MKTTn) 中加入 100 μL 初级富集肉汤。 于 36±2°C 下培养 24±3 小时
|
第 2 天 |
|---|
将 10 μL 二次富集肉汤涂布到木糖赖氨酸脱氧胆酸盐琼脂 (XLD) 和二次分离培养基
及
将 0.1 μL MSRV 或 RVS 的培养物涂布到 XLD 和二次分离培养基
将 XLD 平板于 36±2°C 下培养 24±3 小时
(根据制造商说明培养二次分离培养基)

第 3 天 |
|---|
通过选择充分生长的良好分离菌落或首先在非选择性琼脂(如营养琼脂)上进行传代培养,确认最多 5 个推测性阳性菌落。
于 36±2°C 下培养 24±3 小时

第 4-5 天 |
|---|
生化确认 产酸和产气:三糖铁琼脂 (TSI) | 血清学确认 O、Vi 和 H 抗原检测: |
一种用于食品、饲料产品和环境样品中沙门氏菌属富集、检测和确认的快速实时 PCR 方法:
第 0 天 |
|---|
环境样品• 25 g + 225 mL BPW • 1 份拭子样品 + 10 mL BPW • 1 份海绵涂抹样品 + 100 mL BPW • 1 份擦拭样品 + 225 mL BPW 于 37±1°C 下培养 20-24 小时 | 可可和巧克力产品• 符合 ISO 6887-4:2017 标准的富集肉汤 于 36±2°C 下培养 20-28 小时
• 预热 BPW 于 36±2°C 下培养 22-30 小时 | 生牛肉 |
| 婴儿奶粉 (10g) | 奶粉产品最多 375 g,用 BPW + 6 mg/L 万古霉素按照 1:10 进行稀释 于 37±1°C 下培养 18-22 小时 |
![]() | ![]() | ![]() | ![]() | ![]() | ![]() |
第 1 天 |
|---|




将 SureTect PCR 管加载到 Applied Biosystems 7500 Fast 或 Applied Biosystems QuantStudio 5 PCR 仪上。开始运行 PCR 并在运行结束时审查结果。
(报告阴性结果)

第 2 天 |
|---|
一种快速富集、检测和确认生猪肉和家禽、即食和即食再加热猪肉和家禽、生产环境样品和初级生产样品 (PPS) 中沙门氏菌属和沙门氏菌血清型(鼠伤寒和肠炎)的方法:
第 0 天 |
|---|
生猪肉和即食猪肉和家禽样品:在室温下向 225 ml 添加有 12mg/L 新生霉素的 BPW(ISO-肉蛋白胨)中加入 25g 样品。 于 41.5±1°C 下培养 16±2 小时
| 生产环境样品:向 225 ml BPW(ISO-肉蛋白胨)中加入 25g 生产环境样品。将 1 份拭子样品加入 10 ml BPW(ISO-肉蛋白胨)中。将 1 份海绵涂抹样品加入 100 ml BPW(ISO-肉蛋白胨)中。将 1 次擦拭样品加入 225 ml BPW(ISO-肉蛋白胨)中。 于 41.5±1°C 下培养 16±2 小时 |
![]() | ![]() |
第 1 天 |
|---|
将约 1.5mL 富集物转移至无菌密封管中。

首先,将 10 μL 蛋白酶 K 加入到所需的每支裂解管中。

其次,向裂解管中加入 10 μL 富集物。

将 SureTect 裂解管在 Applied Biosystems SimpliAmp 热循环仪 中于 37±1°C 下孵育 10 分钟,然后于 95±1°C 下孵育 5 分钟,之后于 10±1°C 下孵育 2 分钟。

将 20 μL 转移至 RapidFinder PCR 管。
![]() | ![]() | |
|---|---|---|
7500 Fast PCR 仪 |
| QuantStudio 5 PCR 仪 |
| 将样品加载到 AppliedBiosystems 7500 快速食品安全 PCR 仪上,加入含有无核酸酶无菌水的阴性对照管(预装裂解试剂 1)并开始运行 PCR,在运行结束时审查结果(约 45 分钟) | 或 | 加载到 Applied Biosystems QuantStudio 5 食品安全 PCR 仪上并开始运行 PCR,在运行结束时审查结果(约 50 分钟) |
![]() | ![]() |
报告 PCR 阴性结果,并在 Brilliance™ 沙门氏菌琼脂上培养以确认 PCR 阳性结果。

第 2 天 |
|---|
采用 ISO6579-1:2017 中说明的生化和血清学程序或经 ISO16140-part6:2019 验证的确证性检测来确认在 Brilliance 沙门氏菌琼脂上生长的菌落。
第 0 天 |
|---|
初级生产样品 (PPS):
向 225 mL 添加了碘碘化物的连四硫酸盐 (Hajna) 肉汤(TT 肉汤)中加入 25 g 样品
于 37±1°C 下培养 18±2 小时

第 1 天 |
|---|
将 1 mL 富集样品转移至 9 mL BPW 中
于 37±1°C 下培养 5±1 小时

KingFisher Flex 仪器 |
|---|
将 500 μL 二次富集物加载到 KingFisher Flex 仪器上,

使裂解物在室温下冷却至少 2 分钟,然后转移 20 μL 至 RapidFinder 沙门氏菌 PCR 管中
![]() | ![]() | |
|---|---|---|
7500 Fast PCR 仪 | 或 | QuantStudio 5 PCR 仪 |
| 将 PCR 管加载到 Applied Biosystems 7500 快速食品安全仪上,加入含有无核酸酶无菌水的阴性对照管并开始运行 PCR,在运行结束时审查结果(约 45 分钟) | 将 PCR 管加载到 Applied Biosystems QuantStudio 5 食品安全 PCR 仪上并开始运行 PCR,在运行结束时审查结果(约 50 分钟) | |
![]() | ![]() |
报告 PCR 阴性结果,并在 Brilliance™ 沙门氏菌琼脂上培养以确认 PCR 阳性结果。

第 2 天 |
|---|
采用 Oxoid 沙门氏菌乳胶试验(沙门氏菌属)或者 ISO 6579-1:2017 中说明的生化和血清学程序(肠炎沙门氏菌和伤寒沙门氏菌)或经 ISO 16140-part 6:2019 验证的确证性检测来确认在 Brilliance沙门氏菌琼脂上生长的菌落。
一种用于从广泛的食品、动物饲料和环境样品中富集、检测和确认沙门氏菌属的快速简便方法
第 0 天 |
|---|
食品和饲料 | 环境样品 | 最多 375 g 奶粉、婴儿配方奶粉 * 和婴儿谷类食品 * | 最多 375 g 可可和巧克力产品 | 最多 150 g 动物饲料 |
25 g + 225 mL BPW (ISO) 于 36±2 °C 下培养 20-26 小时 或 25 g + 225 mL 于 41.5±1 °C 下培养 16-22 小时
| • 25 g + 225 mL • 1 份擦拭样品 +225 mL • 1 份拭子样品 + 10 mL • 1 份海绵涂抹样品 + 100 mL
于 36±2 °C 下培养 20-26 小时
或 ONE 肉汤(沙门氏菌) 于 41.5±1 °C 下培养 16-22 小时 | 最多 375 g 于 36±2 °C 下培养 19-23 小时 | 最多 375 g 于 36±2°C 下培养 22-28 小时 或 ISO 6887-4:2017 方法的建议
| 最多 150 g,用 BPW (ISO) + 12 mg/L 新生霉素按照 1:10 进行稀释 于 36±2 °C 下培养 20-26 小时 |

第 1 天 |
|---|
接种到 Brilliance 沙门氏菌琼脂上
于 37±1 °C 下培养 24±2 小时

第 2 天 |
|---|
用 Oxoid 沙门氏菌乳胶试验确认典型菌落是否为沙门氏菌
或
ISO 6579-1:2017 确证性检测或经 ISO 16140-part 6:2019 验证的确证性检测。
* 含或不含益生菌
使用以下链接索取食品微生物学检测方法:沙门氏菌属。